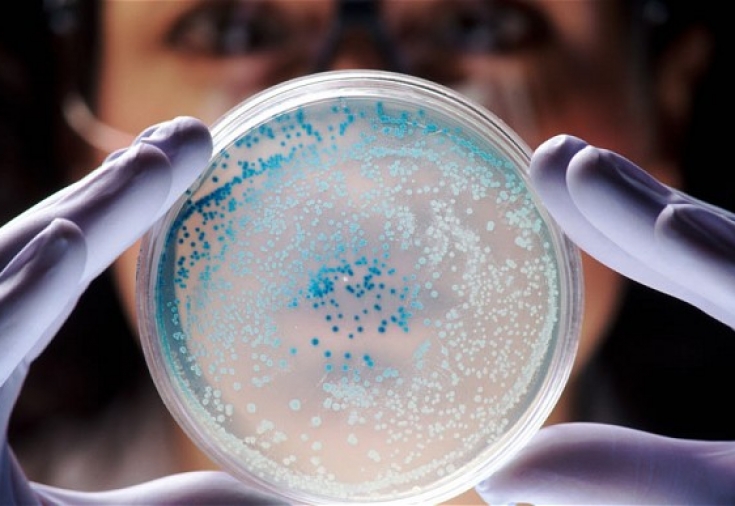

Серед причин зростання ролі мікоплазмової інфекції у збільшенні кількості запальних захворювань сечостатевої системи людини фахівці визначають зміну форм сексуальної поведінки населення та зростання частоти випадків резистентності збудника до традиційних лікарських засобів. Оскільки M. genitalium зустрічається не тільки як моноінфекція, але також і в комплексі з іншими збудниками ІПСШ, питання боротьби з M. genitalium для протидії поширенню ІПСШ серед населення є актуальним.
Ще на початку 1990-х років вітчизняні вчені прогнозували, що найближчим часом в Україні серед інфекцій, що передаються переважно статевим шляхом (ІПСШ), як у структурі захворюваності, так і у списку причинних факторів розвитку порушень репродуктивної сфери, головне місце займуть збудники. групи патогенних мікоплазм (родина Mycoplasmataceae). Цей прогноз базувався на труднощах діагностики, явище високої поширеності в популяції та неадекватності антибіотикотерапії у пацієнтів з ознаками запального ураження нижніх відділів сечостатевої системи.
Хоча з того часу деякі з перерахованих проблем вдалося усунути або детальніше дослідити та вивчити, цей прогноз залишається актуальним і сьогодні. Так, ураження сечостатевої системи мікоплазмової етіології останнім часом зустрічаються частіше і становлять близько 40% запальних захворювань органів сечостатевої системи людини. Подібна ситуація спостерігається не лише в Україні, а й на світовому рівні, особливо серед осіб молодого репродуктивного віку.
На сьогодні серед причин зростання ролі саме мікоплазмової інфекції у збільшенні кількості запальних захворювань сечостатевої системи людини фахівці визначають дещо інші фактори: зміна сексуальних стереотипів, форм сексуальної поведінки населення та зростання частоти випадків резистентності збудника до традиційних лікарських засобів, що застосовуються у спеціалізованих клініках .
Особливості урогенітальних мікоплазмозів
Значна кількість фахівців поєднують запальні захворювання сечостатевої системи людини, що викликаються патогенними мікоплазмами, під однією назвою «урогенітальні мікоплазмози». Сюди включаються запальні ураження сечостатевих органів, які виникають на тлі виявлення M. genitalium, M. hominis та U. urealyticum (а з 2000 р. та U. parvum, яка була виділена з роду U. urealyticum як окремий рід). Використання цього терміну, а також питання ролі окремих мікоплазм як етіологічних факторів розвитку запальних захворювань сечостатевої системи людини є дискутабельним.Хоча логіка використання терміну «урогенітальний мікоплазмоз» простежується (за аналогією з поширеним терміном «урогенітальний хламідіоз» у разі виявлення запального ураження органів сечостатевої системи C. trachomatis), але тоді коректно його застосовувати виключно у разі визначення у пацієнта з явищами уретриту моноінфекції M. genitalium або, в окремих випадках, U. urealyticum.
Ця думка базується на таких фактах. У переліку збудників ІПСШ, визначених Всесвітньою організацією охорони здоров'я (ВООЗ) у базовому документі «Глобальна стратегія профілактики інфекцій, що передаються статевим шляхом, та боротьби з ними, 2006-2015 рр.», із групи мікоплазм названо лише M. genitalium та U. ureal При цьому назва захворювання, яке вони викликають за аналогією з хламідійною інфекцією, не вказано. У той же час, незважаючи на проведення великої кількості наукових досліджень, роль M. hominis, U. parvum та U. urealyticum як етіологічних факторів виникнення запальних захворювань сечостатевої системи не доведена.
Є значна кількість опублікованих досліджень, результати яких можна розглядати як прямий чи опосередкований доказ патогенності цих видів мікоплазм для людського організму та їх прямого впливу на репродуктивну функцію. У результаті проведеного дослідження в Бельгії у 2000 р. у 228 жінок у першому триместрі вагітності за наявності бактеріального вагінозу, Mycoplasma hominis та Ureaplasma urealyticum, було встановлено зв'язок між наявністю цих інфекцій та підвищеним ризиком переривання вагітності на термін до 20 тижнів. Подібні результати були отримані при проведенні дослідження того ж року в Італії: виявлено роль колонізації Ureaplasma urealyticum у розвитку передчасного розриву плодових оболонок. У дослідженні, проведеному 2001 р. у Данії, під час обстеження 484 вагітних було встановлено, що ні бактеріальний вагіноз, ні колонізація Ureaplasma urealyticum були пов'язані з розвитком передчасних пологів.
На сьогодні переважна більшість фахівців - як дерматовенерологів, так і урологів і гінекологів - вважають, що Ureaplasma urealyticum, Ureaplasma parvum та Mycoplasma hominis відносяться до умовно-патогенних мікроорганізмів, а M. genitalium - до облігатних патогенів жінок.
Специфічність урогенітального мікоплазмозу
Показовим є той факт, що за результатами консенсусу фахівців різних спеціальностей у російських клінічних рекомендаціях з діагностики та лікування ІПСШ, зокрема, викликаних урогенітальними мікоплазмами як 2010, так і 2012 року, визначено чіткі показання до призначення антибактеріальної терапії у urealyticum, Ureaplasma parvum та Mycoplasma hominis. Виявлення M. genitalium є прямим показанням для лікування пацієнта, а також його статевих партнерів навіть у разі відсутності ознак запального процесу. Отже, з усіх представників групи мікоплазм тільки M. genitalium можна чітко визначити як збудник урогенітальних інфекцій людини.
M. genitalium є не лише найбільш патогенним представником групи мікоплазм, а й наймолодшим. Хоча вперше цей вид мікоплазм був описаний британськими дослідниками ще у 1981 р. при виділенні його у двох чоловіків з клінічними проявами негонококкового уретриту (НГУ), навіть тепер американські вчені у своїх наукових публікаціях називають M. genitalium новим збудником ІПСШ. З огляду на локалізацію цей мікроорганізм був названий «геніталіум».
Довгий час масштабних епідеміологічних досліджень з M. genitalium у світі практично не проводилося через значні труднощі у її виділенні на живильних середовищах. З 1991 р., коли для діагностики M. genitalium вперше було застосовано метод полімеразної ланцюгової реакції (ПЛР), ця проблема була усунена. На сьогодні саме ПЛР залишається найбільш доступним та ефективним методом виявлення цього збудника ІПСШ як для дослідників, так і для практикуючих лікарів. Саме завдяки впровадженню молекулярних методів діагностики M. genitalium було доведено статевий шлях передачі інфекції, і цей інфекційний агент потрапив до переліку збудників ІПСШ.
Місце та значення M. genitalium серед збудників ІПСШ
Вважається, що M. genitalium є самостійним етіологічним агентом гострого та персистуючого НГУ у чоловіків і є причиною 20-35% усіх випадків нехламідійних НГУ. Це суттєво відрізняє M. genitalium від інших представників цієї групи мікроорганізмів (M. hominis, U. parvum та U. urealyticum), які переважно беруть участь у розвитку запальних процесів органів сечостатевої системи людини в асоціації з іншими збудниками ІПСШ.Питання асоціації M. genitalium з іншими ІПСШ за наявності запальних уражень сечостатевої системи чоловіків і жінок залишається дискутабельним. Так, частина дослідників вважає, що M. genitalium майже ніколи не асоціюється з бактеріальним вагінозом у жінок та кількістю статевих партнерів, інші переконані, що частота виявлення M. genitalium, навпаки, корелює із кількістю статевих партнерів.
Аналіз понад 40 незалежних досліджень серед жінок загальної популяції у різних країнах світу (обстежено понад 13 тис. пацієнток) показав, що частота інфікування серед жінок з низьким ризиком інфікування становить близько 2,0%, що займає проміжні положення між частотою виявлення N gonorrhoeae (0,4%) і C. trachomatis (4,2%) відповідно. У той же час у подібних дослідженнях серед жінок популяцій високого ризику (працівниці секс-індустрії, пацієнтки спеціалізованих клінік з ознаками запальних захворювань сечостатевої системи та ін.) було зафіксовано значно більшу частоту інфікування урогенітального тракту M. genitalium - 7,8%. /p>
Цікавий розкид думок вчених про асоціацію M. genitalium з C. trachomatis як одним із найпоширеніших на сьогодні збудників ІПСШ. Так, існує обґрунтована думка, що M. genitalium існує незалежно від C. trachomatis і зустрічається у клінічній практиці приблизно з такою самою частотою, як хламідійна інфекція. Це твердження пояснюється існуванням конкурентної боротьби між цими патогенними мікроорганізмами за ті самі клітини-мішені, поживні речовини та інші ко-фактори повноцінного існування M. genitalium і C. trachomatis в організмі людини.
З іншого боку, фахівці IUSTI (International Union against Sexually Transmitted Infections - Міжнародної асоціації боротьби з ІПСШ) вважають обов'язковим призначення обстеження на наявність M. genitalium пацієнтам,
Актуальність такого підходу підтверджується і результатами дослідження серед чоловіків, які звернулися до фахівців щодо клінічних проявів ІПСШ. Так, у 53% випадків у цих хворих M. genitalium виявлялася не як моноінфекція, а у вигляді різних бактеріальних та вірусних асоціацій, у тому числі з C. trachomatis.
Таким чином, доведено відносно високий рівень поширення інфікування M. genitalium як у загальній популяції, так і серед представників груп високого ризику інфікування, а також визначено значну роль цієї інфекції у виникненні запальних захворювань нижніх відділів сечостатевої системи. Оскільки M. genitalium зустрічається не тільки як моноінфекція, але також і в комплексі з іншими збудниками ІПСШ, питання боротьби з M. genitalium у системі протидії поширенню ІПСШ серед населення є актуальним.
M. genitalium як фактор порушення репродуктивного здоров'я
На сьогоднішній день не виникає сумнівів щодо впливу M. genitalium на розвиток запальних уражень нижніх відділів сечостатевої системи у чоловіків. Це доведено низкою експериментів на тваринних моделях, а також дослідженнями чоловіків із НГУ. До однозначного висновку про роль M. genitalium у виникненні уретриту у жінок вчені не дійшли, хоча існує низка досліджень, результати яких доводять зв'язок мікроскопічних ознак запалення уретри у жінок з інфікуванням M. genitalium.
З питання розвитку цервіциту на тлі інфікування M. genitalium, етіологічний вплив мікроорганізмів на розвиток цього ураження нижніх відділів сечостатевої системи у жінок вважається практично доведеним. При цьому, за оцінками вчених, рівень підвищення ризику розвитку цервіциту при інфікуванні M. genitalium аналогічний зі ступенем ризику при інфікуванні загальновизнаними збудниками цього захворювання (N. gonorrhoeae і C. trachomatis).
В той же час існують значні відмінності у клінічному перебігу запальних уражень нижніх відділів сечостатевої системи, спричинених M. genitalium та C. trachomatis. Так, зокрема, уретрит, викликаний M. genitalium в гострій маніфестній формі, трапляється частіше, ніж уретрит хламідійної етіології. Взагалі, безсимптомний перебіг для уретриту, спричиненого M. genitalium, не характерний. Це підтверджується результатами дослідження частоти виявлення M. genitalium у чоловіків у різних країнах світу. Так, у дослідженнях різних авторів показано, що M. genitalium була виявлена у 13-42% чоловіків з НГУ, у 18-46% пацієнтів з негонококовим та нехламідійним уретритом і лише у 9% хворих з безсимптомним перебігом уретриту.
Дати однозначну відповідь на питання про вплив M. genitalium на розвиток запальних захворювань верхніх відділів сечостатевої системи у чоловіків та жінок і на безпліддя поки що не можна. Так, про патологічні ураження сечостатевої системи у чоловіків, викликаних M. genitalium, які можуть стати причиною безпліддя, інформації досить мало. Практично немає повідомлень про те, що наявність M. genitalium може спричинити розвиток орхіту, є поодинокі повідомлення про те, що M. genitalium обумовлює формування простатиту як ускладнення хронічного НГУ, що рецидивує. Хоча однозначної відповіді щодо етіологічного впливу M. genitalium на розвиток гострого та хронічного простатиту немає. У той же час є повідомлення, що M. genitalium може приєднуватися до сперматозоїдів та знижувати їхню активність,
Питання запального ураження верхніх відділів репродуктивного тракту у жінок на сьогодні у науковій літературі висвітлено дещо більше. Але, незважаючи на наявність низки досліджень у різних країнах світу, зв'язок між інфікуванням M. genitalium та розвитком запальних захворювань органів малого тазу достовірно не доведено. Так, деякі дослідники вказують, що інфікування M. genitalium достовірно пов'язане з наявністю ендометриту і частота його виявлення в 3 рази вище, ніж у пацієнток, не інфікованих M. genitalium. Інші вчені, проводячи дослідження серед жінок, які мають високий ризик інфікування (працівниці секс-індустрії), такого зв'язку не виявили.
Крім того, на сьогоднішній день не вдалося достовірно довести існування прямої залежності між інфікуванням M. genitalium та виникненням позаматкової вагітності, передчасних пологів та інших негативних наслідків вагітності.
Питання про роль M. genitalium у розвитку вторинної безплідності у жінок можна вважати з'ясованим. Результатами низки досліджень підтверджено існування зв'язку між інфікуванням M. genitalium та розвитком трубної безплідності у жінок, що було доведено в експериментальних дослідженнях на тваринних моделях.
Таким чином, M. genitalium є не лише наймолодшим представником групи урогенітальних мікоплазм, а й найнебезпечнішим із них за впливом на репродуктивне здоров'я людини. Цей мікроорганізм є облігатним патогеном для людини та збудником ІПСШ.
M. genitalium викликає запальні захворювання нижніх відділів сечостатевої системи як у чоловіків, так і у жінок, його виявлення є прямим показанням до лікування пацієнта та його статевих партнерів. Інфікування M. genitalium може викликати вторинне безпліддя як у чоловіків, так і у жінок.
Актуальність застосування заходів боротьби проти поширення M. genitalium у популяції постійно зростає; існує необхідність акцентувати увагу практикуючих лікарів різних спеціальностей (венерологів, урологів, акушерів-гінекологів, сімейних лікарів та інших) на питаннях своєчасної діагностики M. genitalium та лікування пацієнтів, інфікованих збудником ІПСШ, з метою збереження репродуктивного здоров'я населення.
За матеріалами http://health-ua.com

Додати коментар